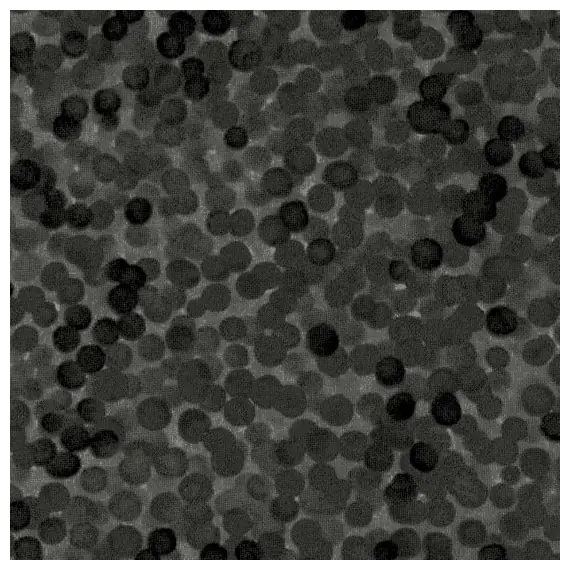
Black - Chroma Dots - W108in

Black - Chroma Dots - W108in
7304-099-Black Wideback
Shipping
Payment Options
Our Advantage
100% Guarantee - Fast Delivery - Quality Products - Australian Owned
Black - Chroma Dots - W108in
100% Cotton Wideback Quilting Fabric 108 Inches / 2.75 Mtrs Wide
Unit measure = 1/2 Mtr
Minimum Purchase = 2 Units or 1 Mtr then in 1/2 mtr increments
No reviews found